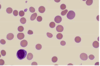
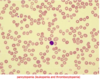

Heme 1 Flashcards
(24 cards)

G6PD deficiency

G6PD deficiency

G6PD deficiency

Sickle cell (target cells)

Sickle cell anemia (sickle cells)

Hgb electrophoresis for sickle cell disease & trait

autosplenectomy d/t sickle cell disease (vaso-oclusion)

reticulocyte (methylene blue)
polychromasia (abnormal grayish-blue RBCs = reticulocytes/premature release of RBCs from marrow)


Normal Mature Erythrocytes


iron metabolism

iron def anemia


iron def anemia
Prussian blue stain of bone marrow for iron

anemia of chronic disease

anemia of chronic disease
increased iron stores in bone marrow on Prussian blue


thalassemias (target cells)

Vitamin b12 & Folate Absorption


Vit b12 & Folate Metabolism

Megaloblastic anemia (vit B12 & folate def.)


Megaloblastic anemia (vit B12 & folate def.)
hypersegmented neutrophils

Hereditary spherocytosis
-normocytic, northern europeans?

Hereditary spherocytosis

microangiopathic hemolytic anemia

aplastic anemia
normal marrow

aplastic anemia
